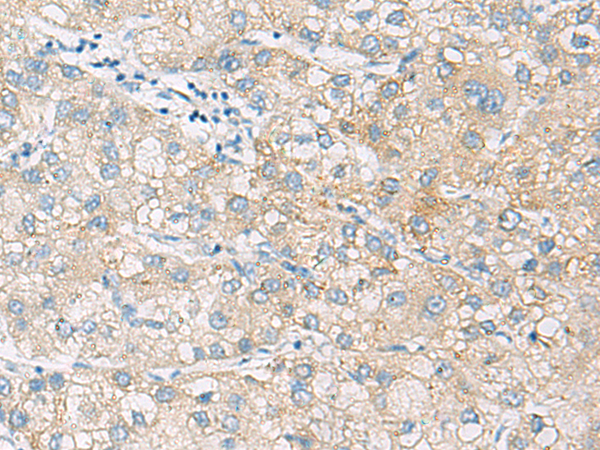
一抗

英文名稱: Anti-NCOA4 rabbit polyclonal antibody
別 名: nuclear receptor coactivator 4; RFG; ELE1; PTC3; ARA70
相關類別: 一抗
儲 存: 冷凍(-20℃)
宿 主: Rabbit
抗 原: NCOA4
反應種屬: Human
標 記 物: Unconjugate
克隆類型: rabbit polyclonal
技術規格
|
Background: |
This gene encodes an androgen receptor coactivator. The encoded protein interacts with the androgen receptor in a ligand-dependent manner to enhance its transcriptional activity. Chromosomal translocations between this gene and the ret tyrosine kinase gene, also located on chromosome 10, have been associated with papillary thyroid carcinoma. Alternatively spliced transcript variants have been described. Pseudogenes are present on chromosomes 4, 5, 10, and 14. |
|
Applications: |
ELISA, IHC |
|
Name of antibody: |
NCOA4 |
|
Immunogen: |
Fusion protein of human NCOA4 |
|
Full name: |
nuclear receptor coactivator 4 |
|
Synonyms: |
RFG; ELE1; PTC3; ARA70 |
|
SwissProt: |
Q13772 |
|
ELISA Recommended dilution: |
5000-10000 |
|
IHC positive control: |
Human thyroid cancer and Human liver cancer |
|
IHC Recommend dilution: |
100-300 |


 購物車
購物車 幫助
幫助
 021-54845833/15800441009
021-54845833/15800441009